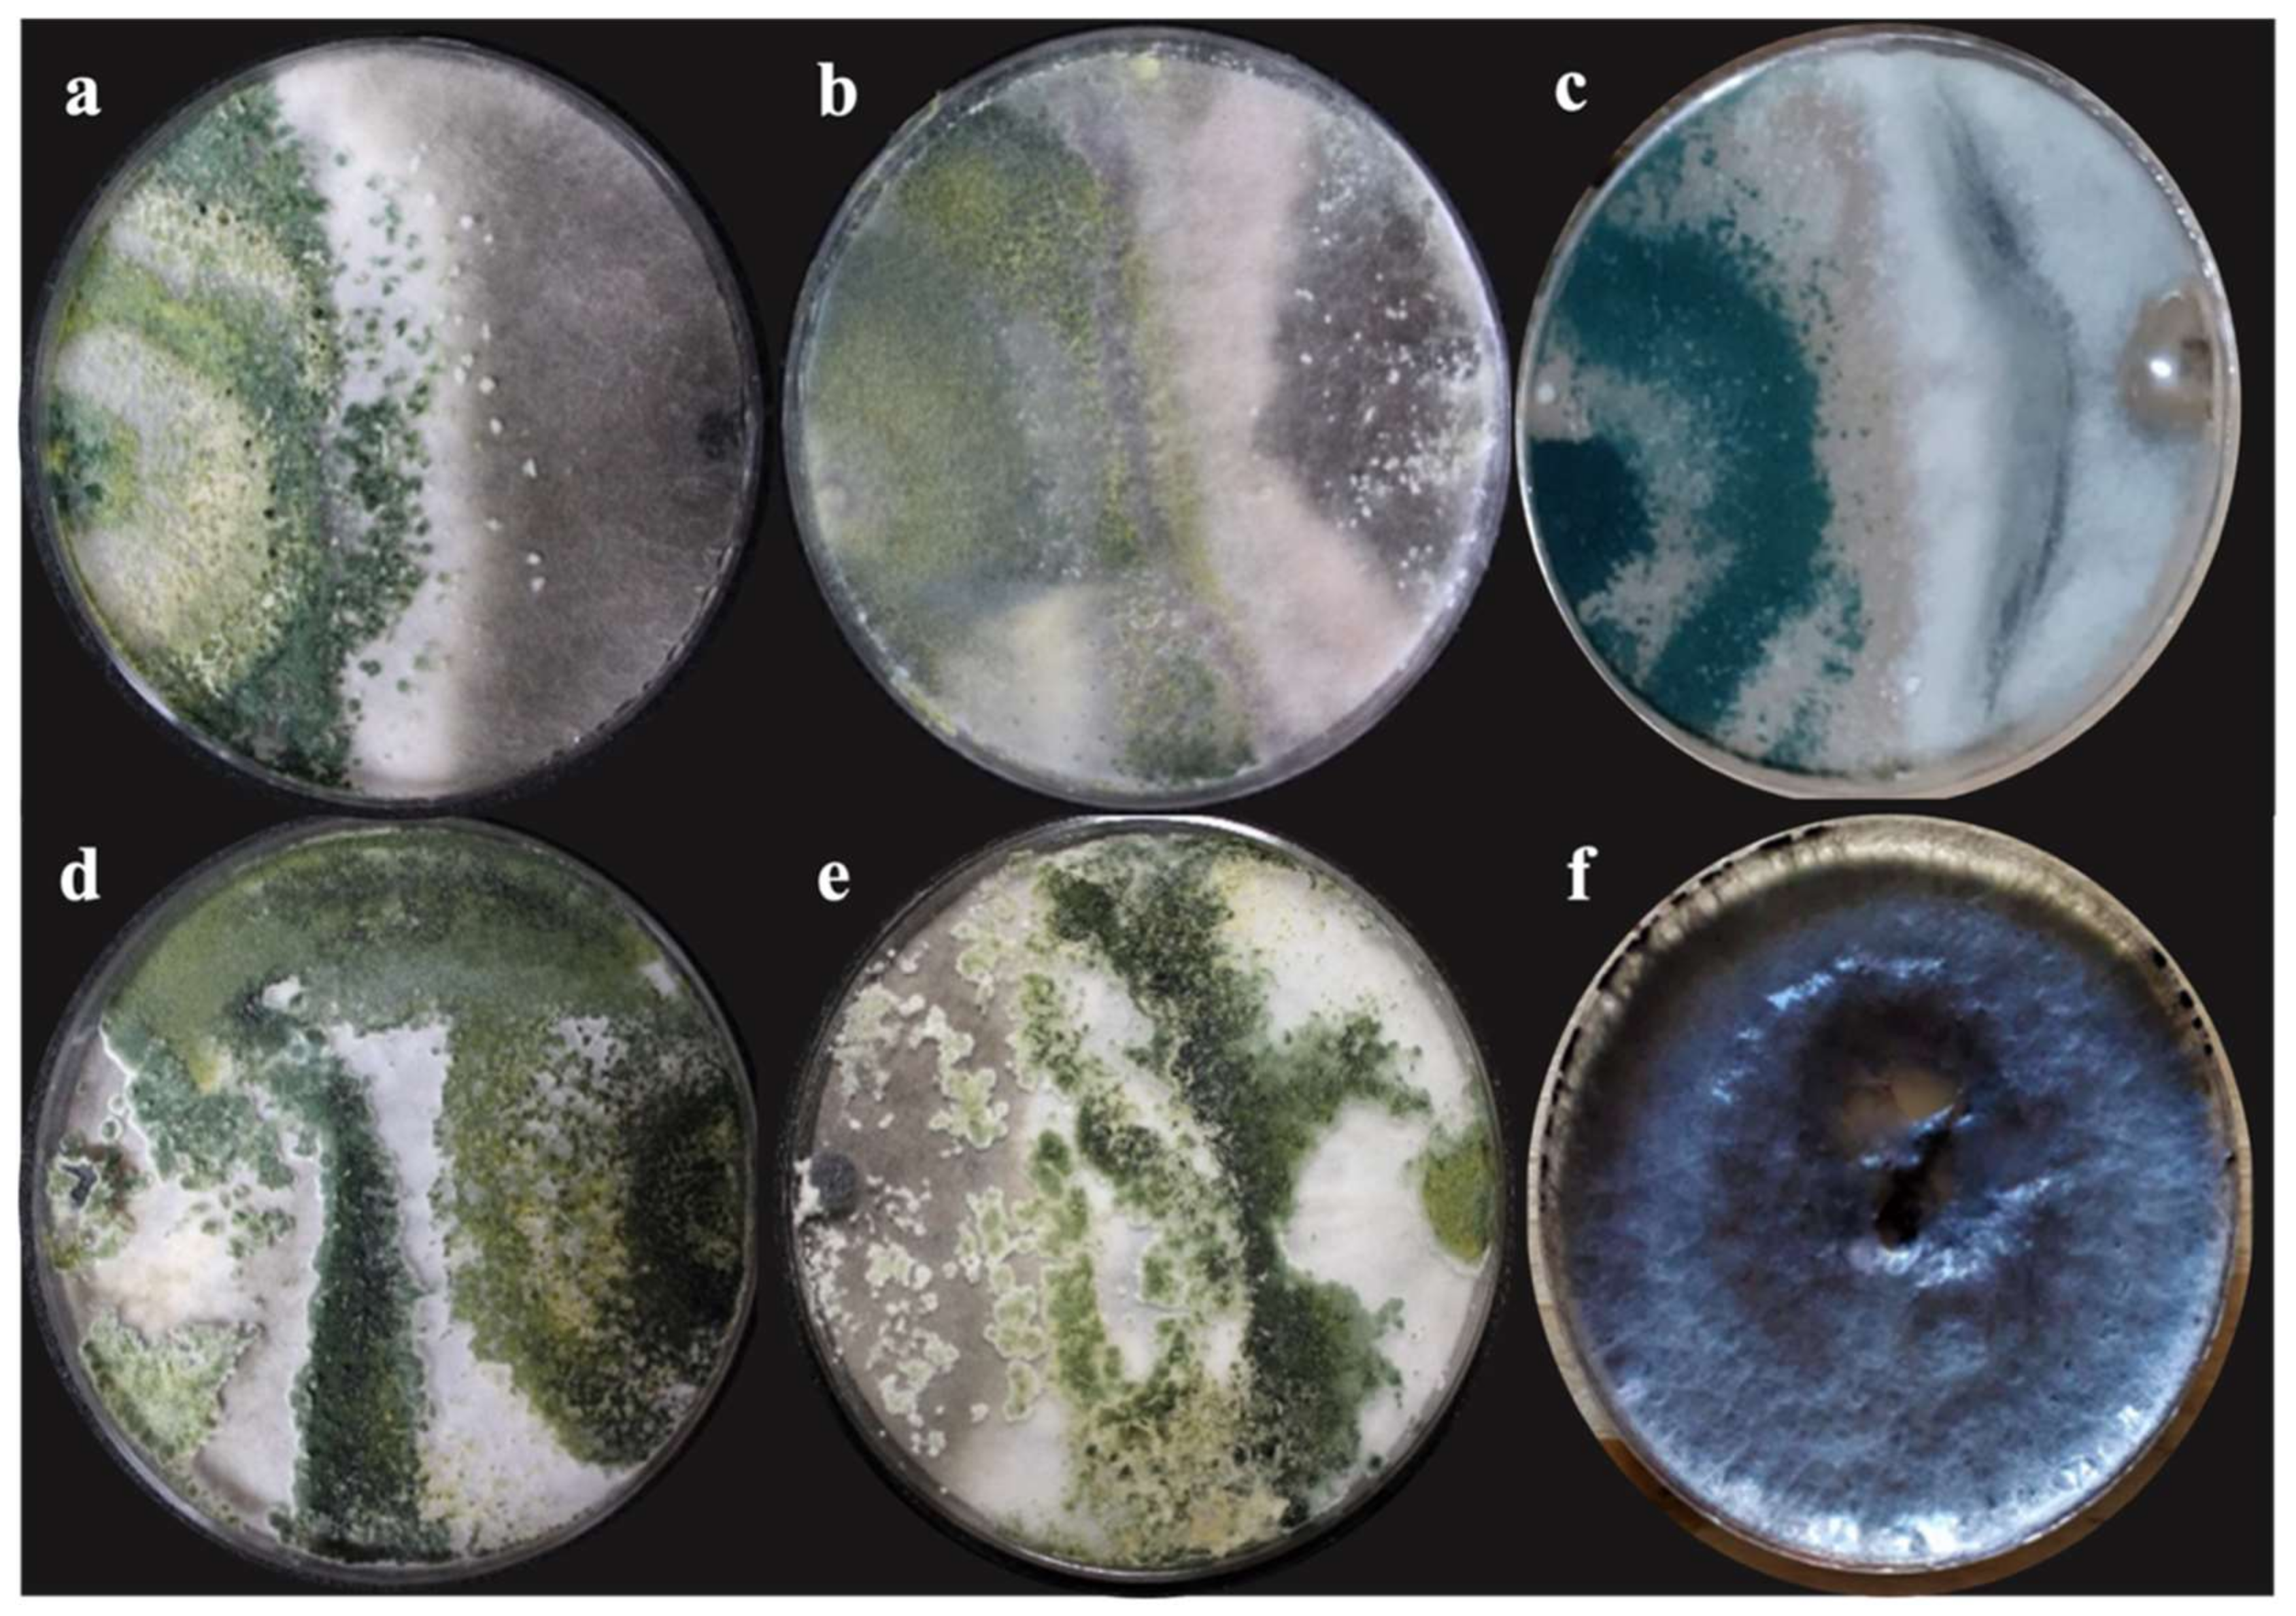

Biological Control of Charcoal Rot in Peanut Crop through Strains of Trichoderma spp., in Puebla, Mexico
Abstract
1. Introduction
2. Materials and Methods
2.1. Area of Isolation
2.2. DNA Extraction, PCR Amplification, and Sequencing
2.3. Pathogenicity Tests
2.4. In Vitro Assessment of Antagonistic Capacity of Trichoderma spp.
- y = is the distance
- m = slope
- x = is time
- b = the constant factor.
- PIRG = Percent inhibition of radial growth.
- R1 = Radial growth (mm) of M. phaseolina without Trichoderma spp.
- R2 = Radial growth (mm) of M. phaseolina with Trichoderma spp.
2.5. Field Experiment: Evaluation of Antagonism
2.6. Statistical Analysis
3. Results
3.1. Isolation, Characterization, and Identification of the Causative Agent of Charcoal Rot
3.2. Pathogenicity Tests
3.3. Percentage of Growth Inhibition In Vitro
3.4. Evaluation of Antagonism in Field
4. Discussion
5. Conclusions
Author Contributions
Funding
Institutional Review Board Statement
Informed Consent Statement
Data Availability Statement
Acknowledgments
Conflicts of Interest
References
- Desmae, H.; Janila, P.; Okori, P.; Pandey, M.K.; Motagi, B.N.; Monyo, E.; Mponda, O.; Okello, D.; Sako, D.; Echeckwu, C.; et al. Genetics, genomics and breeding of groundnut (Arachis hypogaea L.). Plant Breed. 2018, 138, 425–444. [Google Scholar] [CrossRef]
- Ijaz, M.; Perveen, S.; Nawaz, A.; Ul-Allah, S.; Sattar, A.; Sher, A.; Ahmad, S.; Nawaz, F.; Rasheed, I. Eco-friendly alternatives to synthetic fertilizers for maximizing peanut (Arachis hypogea L.) production under arid regions in Punjab, Pakistan. J. Plant Nutr. 2020, 43, 762–772. [Google Scholar] [CrossRef]
- United States Department of Agriculture. Available online: https://www.fas.usda.gov/data (accessed on 8 October 2021).
- Food and Agriculture Organization. Available online: https://www.fao.org/faostat/en/#data/QCL (accessed on 8 October 2021).
- Servicio de Información Agroalimentaria y Pesquera. Available online: https://www.gob.mx/siap (accessed on 8 October 2021).
- Deepthi, K.C.; Reddy, E.N.P. Stem rot disease of groundnut (Arachis hypogaea L.) induced by Sclerotium rolfsii and its management. Int. J. Life Sci. Biotechnol. Pharm. Res. 2013, 2, 2250–3137. [Google Scholar]
- Martínez-Salgado, S.J.; Romero-Arenas, O.; Morales-Mora, L.A.; Luna-Cruz, A.; Rivera-Tapia, J.A.; Silva-Rojas, H.V.; Andrade-Hoyos, P. First report of Macrophomina phaseolina causing charcoal rot of peanut (Arachis hypogaea L.) in Mexico. Plant Dis. 2021. Accepted for publication 18 March 2021. [Google Scholar] [CrossRef]
- Babu, B.K.; Babu, T.K.; Sharma, R. Molecular identification of microbes: I. Macrophomina phaseolina. In Analyzing Microbes; Arora, D., Das, S., Sukumar, M., Eds.; Springer: Berlin/Heidelberg, Germany, 2013; pp. 93–97. ISBN 978-3-642-34409-1. [Google Scholar]
- Ghosh, T.; Biswas, M.K.; Guin, C.; Roy, P. A review on characterization, therapeutic approaches, and pathogenesis of Macrophomina phaseolina. Plant Cell Biotechnol. Mol. Biol 2018, 19, 72–84. [Google Scholar]
- Basandrai, A.K.; Pandey, A.K.; Somta, P.; Basandrai, D. Macrophomina phaseolina–host interface: Insights into an emerging dry root rot pathogen of mungbean and urdbean, and its mitigation strategies. Plant Pathol. 2021, 70, 1263–1275. [Google Scholar] [CrossRef]
- Lakhran, L.; Ahir, R.R.; Choudhary, M.; Choudhary, S. Isolation, purification, identification, and pathogenicity of Macrophomina phaseolina (Tassi) Goid caused dry root rot of chickpea. J. Pharmacogn. Phytochem. 2018, 7, 3314–3317. [Google Scholar]
- Marquez, N.; Giachero, M.L.; Declerck, S.; Ducasse, D.A. Macrophomina phaseolina: General characteristics of pathogenicity and methods of control. Front. Plant Sci. 2021, 12, 634397. [Google Scholar] [CrossRef] [PubMed]
- Standish, J.R.; Culbreath, A.K.; Branch, W.D.; Brenneman, T.B. Disease, and yield response of a stem-rot-resistant and susceptible peanut cultivar under varying fungicide inputs. Plant Dis. 2019, 103, 2781–2785. [Google Scholar] [CrossRef] [PubMed]
- Zongo, A.; Konate, A.K.; Koïta, K.; Sawadogo, M.; Sankara, P.; Ntare, B.R.; Desmae, H. Diallel analysis of early leaf spot (Cercospora arachidicola Hori) disease resistance in groundnut. Agronomy 2019, 9, 15. [Google Scholar] [CrossRef] [PubMed]
- Pérez-Torres, E.; Bernal-Cabrera, A.; Milanés-Virelles, P.; Sierra-Reyes, Y.; Leiva-Mora, M.; Marín-Guerra, S.; Monteagudo-Hernández, O. Eficiencia de Trichoderma harzianum (cepa a-34) y sus filtrados en el control de tres enfermedades fúngicas foliares en arroz. Bioagro 2018, 3, 17–26. [Google Scholar]
- Contreras-Cornejo, H.A.; Macías-Rodríguez, L.; del-Val, E.; Larsen, J. Interactions of Trichoderma with plants, insects, and plant pathogen microorganisms: Chemical and molecular bases. In Co-Evolution of Secondary Metabolites; Merillon, J.M., Ramawat, K., Eds.; Springer: Cham, Switzerland, 2019; pp. 1–28. [Google Scholar]
- Nawrocka, J.; Szczechy, M.; Malolepsza, U. Trichoderma atroviride enhances phenolic synthesis and cucumber protection against Rhizoctonia solani. Plant Protect. Sci. 2018, 54, 17–23. [Google Scholar] [CrossRef]
- Andrade-Hoyos, P.; Silva-Rojas, H.V.; Romero-Arenas, O. Endophytic Trichoderma species isolated from Persea americana and Cinnamomum verum roots reduce symptoms caused by Phytophthora cinnamomi in avocado. Plants 2020, 9, 1220. [Google Scholar] [CrossRef]
- Hernández-Melchor, D.J.; Ferrera-Cerrato, R.; Alarcón, A. Trichoderma: Importancia grícola, biotecnológica, y sistemas de fermentación para producir biomasa y enzimas de interés industrial. Chil. J. Agric. Anim. Sci. 2019, 35, 95–112. [Google Scholar] [CrossRef]
- Khaledi, N.; Taheri, P. Biocontrol mechanisms of Trichoderma harzianum against soybean charcoal rot caused by Macrophomina phaseolina. J. Plant Prot. Res. 2016, 56, 21–31. [Google Scholar] [CrossRef]
- Das, I.K.; Indira, S.; Annapurna, A.; Seetharama, N. Biocontrol of charcoal rot in sorghum by Pseudomonas fluorescent associated with the rhizosphere. Crop. Prot. 2008, 27, 1407–1414. [Google Scholar] [CrossRef]
- Hussain, S.; Ghaffar, A.; Aslam, M. Biological control of Macrophomina phaseolina charcoal rot of sunflower and mung bean. J. Phytopathol. 1990, 130, 157–160. [Google Scholar] [CrossRef]
- García, E. Modificaciones al Sistema de Clasificación Climática de Köppen; Serie Libros; Instituto de Geografía UNAM: México, Mexico, 2004; Volume 6. [Google Scholar]
- Morales-Mora, L.A.; Andrade-Hoyos, P.; Valencia-de Ita, M.A.; Romero-Arenas, O.; Silva-Rojas, H.V.; Contreras-Paredes, C.A. Characterization of strawberry associated fungi and in vitro antagonistic effect of Trichoderma harzianum. Rev. Mex. Fitopatol. 2020, 38, 434–449. [Google Scholar] [CrossRef]
- Barnett, H.L.; Hunter, B.B. Illustrated Genera of Imperfect Fungi; The American Phytopathological Society: Saint Paul, MN, USA, 1998. [Google Scholar]
- Samson, R.A.; Visagie, C.M.; Houbraken, J.; Hong, S.B.; Hubka, V.; Klaassen, C.H.; Perrone, G.; Seifert, K.A.; Susca, A.; Tanney, J.B.; et al. Phylogeny, identification and nomenclature of the genus Aspergillus. Stud. Mycol. 2014, 78, 141–173. [Google Scholar] [CrossRef]
- Doyle, J.J.; Doyle, J.L. Isolation of plant DNA from fresh tissue. Focus 1990, 12, 13–15. [Google Scholar]
- Rivera-Jiménez, M.N.; Zavaleta-Mancera, H.A.; Rebollar-Alviter, A.; Aguilar-Rincón, V.H.; García-de los Santos, G.; Vaquera-Huerta, H.; Silva-Rojas, H.V. Phylogenetics and histology provide insight into damping-off infections of ‘Poblano’ pepper seedlings caused by Fusarium wilt in greenhouses. Mycol. Prog. 2018, 17, 1237–1249. [Google Scholar] [CrossRef]
- White, T.J. PCR Protocols: A Guide to Methods and Applications; Academic Press: San Diego, CA, USA, 1990. [Google Scholar]
- Juárez-Vázquez, S.B.; Silva-Rojas, H.V.; Rebollar-Alviter, A.; Maidana-Ojeda, M.; Osnaya-González, M.; Fuentes-Aragón, D. Phylogenetic and morphological identification of Colletotrichum godetiae, a novel pathogen causing anthracnose on loquat fruit (Eriobotrya japonica). J. Plant. Dis. Prot. 2019, 126, 593–598. [Google Scholar] [CrossRef]
- Campbell, M.A.; Li, Z.; Buck, J.W. Development of southern stem canker disease on soybean seedlings in the greenhouse using a modified toothpick inoculation assay. Crop. Prot. 2017, 100, 57–64. [Google Scholar] [CrossRef]
- Zeravakis, G.; Philippoussis, A.; Ioannidou, S.; Diamantopoulou, P. Mycelium growth kinetics and optimal temperature conditions for the cultivation of edible mushroom species on lignocellulosic substrates. Folia Microbiol. 2001, 46, 231. [Google Scholar] [CrossRef]
- Andrade-Hoyos, P.; Luna-Cruz, L.; Osorio-Hernández, E.; Molina-Gayosso, E.; Landero-Valenzuela, N.; Barrales-Cureño, H.J. Antagonismo de Trichoderma spp. vs. Hongos Asociados a la Marchitez de Chile. Rev. Mex. Cienc. Agric. 2019, 10, 1259–1272. [Google Scholar] [CrossRef]
- Bell, D.K.; Wells, H.D.; Markham, C.R. In vitro antagonism of Trichoderma species against six fungal plant pathogens. Phytopathology 1982, 72, 379–382. [Google Scholar] [CrossRef]
- Perveen, K.; Haseeb, A.; Shukla, P.K. Management of Sclerotinia sclerotiorum on Mentha arvensis cv. Gomti. J. Mycol. Plant. Pathol. 2007, 37, 33–36. [Google Scholar]
- Bokhari, N.A.; Perveen, K. Antagonistic action of Trichoderma harzianum and Trichoderma viride against Fusarium solani causing root rot of tomato. Afr. J. Microbiol. Res. 2012, 6, 7193–7197. [Google Scholar]
- Zamurrad, M.; Tariq, M.; Shah, F.H.; Subhani, A.; Ijaz, M.; Iqbal, M.S.; Koukab, M. Performance based evaluation of groundnut genotypes under medium rainfall conditions of chakwal. J. Agric. Food Appl. Sci. 2013, 1, 9–12. [Google Scholar]
- Kumar, P.; Gaur, V.K.; Meena, A.K. Screening of different Macrophomina phaseolina on susceptible (RMG-62) variety of mungbean. Inter. J. Pure Appl. Biosci. 2017, 5, 698–702. [Google Scholar] [CrossRef]
- Zhang, J.Q.; Zhu, Z.D.; Duan, C.X.; Wang, X.M.; Li, H.J. First report of charcoal rot caused by Macrophomina phaseolina on Mungbean in China. Plant Dis. 2011, 95, 872. [Google Scholar] [CrossRef]
- Pandey, A.K.; Burlakoti, R.R.; Rathore, A.; Nair, R.M. Morphological and molecular characterization of Macrophomina phaseolina isolated from three legume crops and evaluation of mungbean genotypes for resistance to dry root rot. Crop. Prot. 2020, 127, 104962. [Google Scholar] [CrossRef]
- Hajlaoui, M.R.; Monia, M.H.; Sayeh, M.; Zarrouk, I.; Jemmali, A.; Koikie, S.T. First report of Macrophomina phaseolina causing charcoal rot of strawberry in Tunisia. New Dis. Rep. 2015, 32, 14. [Google Scholar] [CrossRef]
- Salvatore, M.M.; Félix, C.; Lima, F.; Ferreira, V.; Naviglio, D.; Salvatore, F.; Duarte, A.S.; Alves, A.; Andolfi, A.; Esteves, A.C. Secondary metabolites produced by Macrophomina phaseolina isolated from Eucalyptus globulus. Agriculture 2020, 10, 72. [Google Scholar] [CrossRef]
- Khan, S.N. Macrophomina phaseolina as causal agent for charcoal rot of sunflower. Mycopath 2007, 5, 111–118. [Google Scholar]
- Cubilla-Ríos, A.A.; Ruíz-Díaz-Mendoza, D.D.; Romero-Rodríguez, M.C.; Flores-Giubi, M.E.; Barúa-Chamorro, J.E. Antibiosis of proteins and metabolites of three species of Trichoderma against paraguayan isolates of Macrophomina phaseolina. Agron. Mesoam. 2019, 30, 63–77. [Google Scholar] [CrossRef]
- Sreedevi, B.; Charitha-Devi, M.; Saigopal, D.V.R. Isolation and screening of effective Trichoderma spp. against the root rot pathogen Macrophomina phaseolina. J. Agric. Technol. 2011, 7, 623–635. [Google Scholar]
- Shoaib, A.; Munir, M.; Javaid, A.; Awan, Z.A.; Rafiq, M. Anti-mycotic potential of Trichoderma spp. and leaf biomass of Azadirachta indica against the charcoal rot pathogen, Macrophomina phaseolina (Tassi) Goid in cowpea. Egypt J. Biol. Pest. Control 2018, 28, 26. [Google Scholar] [CrossRef]
- Pitson, S.M.; Seviour, R.J.; McDougall, B.M. Β-glucanasa fúngica no celulolítica: Su fisiología y regulación. Enzym. Microb. Tecnol. 1993, 15, 178–192. [Google Scholar] [CrossRef]
- Chang, K.F.; Hwang, S.F.; Wang, H.; Turnbull, G.; Howard, R. Etiology and biological control of Sclerotinia blight of coneflower using Trichoderma species. Plant Pathol. J. 2006, 5, 15–19. [Google Scholar] [CrossRef][Green Version]
- Khalili, E.; Javed, M.A.; Huyop, F.; Rayatpanah, S.; Jamshidi, S.; Wahab, R.A. Evaluation of Trichoderma isolates as potential biological control agent against soybean charcoal rot disease caused by Macrophomina phaseolina. Biotechnol. Biotechnol. Equip. 2016, 30, 479–488. [Google Scholar] [CrossRef]
- Woo, S.L.; Scala, F.; Ruocco, M.; Lorito, M. The molecular biology of the interactions between Trichoderma, phytopathogenic fungi and plants. Phytopathology 2006, 96, 181–185. [Google Scholar] [CrossRef] [PubMed]
- Ruangwong, O.-U.; Pornsuriya, C.; Pitija, K.; Sunpapao, A. Biocontrol mechanisms of Trichoderma koningiopsis PSU3-2 against postharvest anthracnose of Chili Pepper. J. Fungi 2021, 7, 276. [Google Scholar] [CrossRef]
- Etebarian, H.R. Evaluation of Trichoderma Isolates for biological control of charcoal stem rot in melon caused by Macrophomina phaseolina. J. Agric. Sci. Technol. 2006, 8, 243–250. [Google Scholar]
- Khan, M.R.; Haque, Z.; Rasool, F.; Salati, K.; Khan, U.; Mohiddin, F.A.; Zuhaib, M. Management of root-rot disease complex of mungbean caused by Macrophomina phaseolina and Rhizoctonia solani through soil application of Trichoderma spp. Crop. Prot. 2019, 119, 24–29. [Google Scholar] [CrossRef]
- Dubey, S.C.; Suresh, M.; Singh, B. Evaluation of Trichoderma species against Fusarium oxysporum f. sp. ciceris for integrated management of chickpea wilt. Biol. Control 2007, 40, 118–127. [Google Scholar] [CrossRef]
- Harman, G.; Howell, C.; Viterbo, A.; Chet, I.; Lorito, M. Trichoderma species—Opportunistic, avirulent plant symbionts. Nat. Rev. Microbiol. 2004, 2, 43–56. [Google Scholar] [CrossRef]
- Harman, G.E. Overview of mechanisms and uses of Trichoderma spp. Phytopathology 2006, 96, 190–194. [Google Scholar] [CrossRef]
- Tsegaye-Redda, E.T.; Ma, J.; Mei, J.; Li, M.; Wu, B.; Jiang, X. Biological control of soilborne pathogens (Fusarium oxysporum f. sp. cucumerinum) of cucumber (Cucumis sativus) by Trichoderma sp. J. Life Sci. 2018, 12, 1–12. [Google Scholar] [CrossRef]
- Osman, H.A.; Ameen, H.H.; Mohamed, M.; Elkelany, U.S. Efficacy of integrated microorganisms in controlling root-knot nematode Meloidogyne javanica infecting peanut plants under field conditions. Bull. Natl. Res. Cent. 2020, 44, 134. [Google Scholar] [CrossRef]
- Dania, V.O.; Eze, S.E. Using Trichoderma species in combination with cattle dung as soil amendment improves yield and reduces pre-harvest aflatoxin contamination in groundnut. J. Agric. Sci. 2020, 42, 449–461. [Google Scholar] [CrossRef]

| Class | Class Features |
|---|---|
| I | Trichoderma completely overgrew the M. phaseolina and covered the entire medium surface. |
| II | Trichoderma overgrew at least two-thirds of the medium surface. |
| III | Trichoderma and the M. phaseolina each colonized approximately one-half of the medium surface and neither organism appeared to dominate the other. |
| IV | M. phaseolina colonized at least two-thirds of the medium surface and appeared to withstand encroachment by Trichoderma. |
| V | M. phaseolina completely overgrew the Trichoderma and occupied the entire medium surface. |
| Name | Development Rate (mm/hour) * | Growth Rate (cm/d−1) * | PICR * | Class Antagonism |
|---|---|---|---|---|
| T. harzianum (T-H3) | 2.17 ± 0.095 a | 1.32 ± 0.04 a | ||
| T. asperellum (T-AS1) | 1.86 ± 0.033 b | 2.16 ± 0.017 a | ||
| T. hamatum (T-A12) | 1.60 ± 0.05 c | 2.14 ± 0.01 a | ||
| T. koningiopsis (T-K11) | 2.18 ± 0.035 a | 2.23 ± 0.013 a | ||
| T. harzianum (Th-Ah) | 1.59 ± 0.04 c | 2.06 ± 0.068 a | ||
| M. phaseolina (PUE 4.0) | 1.44 ± 0.04 c | 1.67 ± 0.054 b | ||
| M. phaseolina (PUE 4.0) vs. T. harzianum (T-H3) | 63.55 ± 0.88 ab | I | ||
| M. phaseolina (PUE 4.0) vs. T. asperellum (T-AS1) | 53.33 ± 0.76 bc | II | ||
| M. phaseolina (PUE 4.0) vs. T. hamatum (T-A12) | 51.55 ± 2.47 c | II | ||
| M. phaseolina (PUE 4.0) vs. T. koningiopsis (T-K11) | 71.11 ± 0.44 a | I | ||
| M. phaseolina (PUE 4.0) vs. T. harzianum (Th-Ah) | 59.11 ± 4.23 bc | II |
| Treatments | Incidence of Disease | Total Fresh Weight per Plant (g) * | Dry Weight of Pods per Plant (g) * | Number of Pods per Plant * | Weight of 100 Grains (g) * |
|---|---|---|---|---|---|
| M ± SE | M ± SE | M ± SE | M ± SE | ||
| M. phaseolina | 3 | 673.20 ± 52.04 e | 54.80 ± 10.74 b | 11.00 ± 0.28 e | 58 ± 0.09 f |
| M. phaseolina vs. T. hamatum | 2 | 909.80 ± 62.6 c | 112.60 ± 14.05 a | 14.60 ± 0.04 c | 61 ± 0.02 e |
| M. phaseolina vs. T. asperellum | 2 | 970.60 ± 132.71 bc | 115.60 ± 7.83 a | 14.88 ± 0.61 bc | 62 ± 0.04 d |
| M. phaseolina vs. T. koningiopsis | 1 | 1417.60 ± 101.61 a | 124.20 ± 8.60 a | 16.01 ± 0.71 a | 64.8 ± 0.01 a |
| M. phaseolina vs. T. harzianum | 2 | 1018.60 ± 55.52 b | 116.20 ± 9.15 a | 15.35 ± 0.6 b | 63 ± 0.04 c |
| M. phaseolina vs. T. harzianum (native) | 2 | 1007.80 ± 74.28 bc | 123.00 ± 5.27 a | 15.13 ± 0.81 bc | 62.4 ± 0.04 cd |
| M. phaseolina vs. Cercobin® | 2 | 1077.00 ± 112.81 b | 120.60 ± 18.60 a | 15.22 ± 0.86 b | 64 ± 0.03 b |
| Control | 0 | 712.20 ± 105.86 d | 88.00 ± 7.62 b | 13.89 ± 0.52 d | 60.9 ± 0.04 e |
Publisher’s Note: MDPI stays neutral with regard to jurisdictional claims in published maps and institutional affiliations. |
© 2021 by the authors. Licensee MDPI, Basel, Switzerland. This article is an open access article distributed under the terms and conditions of the Creative Commons Attribution (CC BY) license (https://creativecommons.org/licenses/by/4.0/).
Share and Cite
Martínez-Salgado, S.J.; Andrade-Hoyos, P.; Parraguirre Lezama, C.; Rivera-Tapia, A.; Luna-Cruz, A.; Romero-Arenas, O. Biological Control of Charcoal Rot in Peanut Crop through Strains of Trichoderma spp., in Puebla, Mexico. Plants 2021, 10, 2630. https://doi.org/10.3390/plants10122630
Martínez-Salgado SJ, Andrade-Hoyos P, Parraguirre Lezama C, Rivera-Tapia A, Luna-Cruz A, Romero-Arenas O. Biological Control of Charcoal Rot in Peanut Crop through Strains of Trichoderma spp., in Puebla, Mexico. Plants. 2021; 10(12):2630. https://doi.org/10.3390/plants10122630
Chicago/Turabian StyleMartínez-Salgado, Saira Jazmín, Petra Andrade-Hoyos, Conrado Parraguirre Lezama, Antonio Rivera-Tapia, Alfonso Luna-Cruz, and Omar Romero-Arenas. 2021. "Biological Control of Charcoal Rot in Peanut Crop through Strains of Trichoderma spp., in Puebla, Mexico" Plants 10, no. 12: 2630. https://doi.org/10.3390/plants10122630
APA StyleMartínez-Salgado, S. J., Andrade-Hoyos, P., Parraguirre Lezama, C., Rivera-Tapia, A., Luna-Cruz, A., & Romero-Arenas, O. (2021). Biological Control of Charcoal Rot in Peanut Crop through Strains of Trichoderma spp., in Puebla, Mexico. Plants, 10(12), 2630. https://doi.org/10.3390/plants10122630

